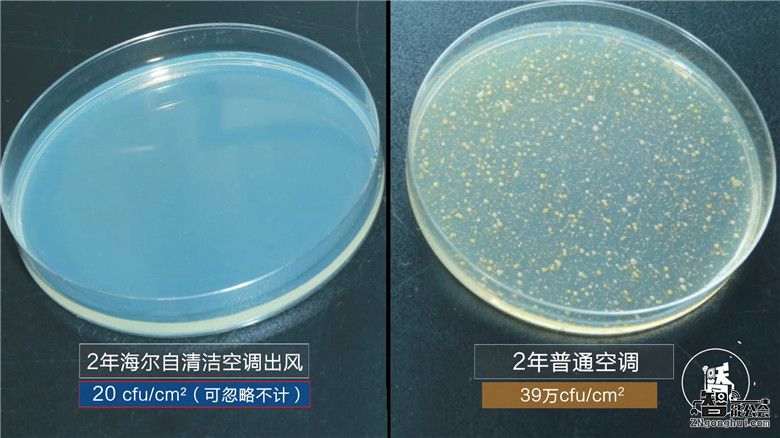
海尔苏宁全球首发智能自清洁空调新品 将成第一型号 智能公会

4月25日,海尔空调联合苏宁云商在南京全球首发净铂智能自清洁空调。双方宣布建立深度战略合作关系,通过大数据开放联合研发,共同推动行业智能自清洁空调普及。继变频空调普及之后,智能自清洁将成为空调行业的新的增长点。

智能自清洁普及为行业“破局”
经历数年的去库存高压后,空调业在2016年实现逆转,实现产销同增,除天时地利因素外,企业自身智能变革的“人和”因素起了重要作用。国家信息中心信息资源开发部副主任蔡莹指出,智能空调已成为继变频空调之后国内空调行业又一个新的增长点。产业在线数据显示,智能空调规模迅猛增长复合增长率65%,市场占比已提升至25%。其中,海尔空调开辟出的智能自清洁这一细分市场表现尤为亮眼,已渐成普及之势。

随着90后逐步成为主力消费群体,个性化、智能化、互动化的产品将逐步成为主流趋势。此次发布的海尔净铂智能自清洁空调充分满足用户需求,不仅能够为用户提供洁净健康的空气,更成为整个家居环境与用户交流的平台。

海尔作为行业最早探索和实践智慧家庭的品牌,目前已经进入智慧家庭3.0阶段,智能产品由以往的被动服务转变为主动的场景化服务。海尔空调智能大数据已发展至500亿+,可精准定位用户需求,原创出智能自清洁等产品。苏宁云商则拥有完整的“智慧零售”体系,旗下3600家线下门店、苏宁易购主站、天猫苏宁旗舰店两个线上平台,全渠道把控消费趋势。双方资源共享,将进一步推动智能自清洁空调的普及。

场景化应用助力智慧家庭普及
今年3月,海尔发布了由整套全互通互联智慧家电构成的全球首个智慧家庭,涉及到客厅、厨房、浴室、卧室不同物理空间的首批161个智慧生活场景,将智慧生活变成现实。而此次海尔空调与苏宁跨品牌共创的海尔净铂智能自清洁新品,依托软件、硬件双重实力,实现了更多智慧生活场景的迭代,助力智慧家庭普及。

在软件方面,海尔净铂新品实现了“苏宁智能”和“海尔好空气”APP双直连,让用户可同时共享双APP提供的场景化服务。利用“苏宁智能”APP,用户在回家路上就可以远程设置归家模式,联动智能门锁、智能灯等硬件,一进家门不再是漆黑冰冷,立刻就能享受到舒适温度;睡觉时也可设置睡眠模式,联动卧室智能硬件,自动关灯并设置最佳入眠温度,一觉安眠到天亮。

在硬件方面,海尔净铂空调内外机都能自清洁。依托海尔原创专利自清洁技术,利用水结霜冷膨胀剥离污垢,实现高达99.9%抗菌。在现场,海尔还设置了自清洁空调体验区,通过吹白毛巾和中科院视频展示看得见的干净。目前,海尔自清洁空调吹白毛巾演示已扩展至全国1000家终端卖场,实现由“直播洗澡”到“吹白毛巾”的交互升级,满足用户对健康空气的需求。
目前,海尔在苏宁云商渠道的一系列数据也印证了自清洁空调的行业普及趋势,海尔智能空调苏宁渠道占比高达90%以上,居行业首位。海尔智能自清洁空调2016年在苏宁较2015年增幅60%,2017年智能自清洁空调实现翻番增长。自清洁空调已成为苏宁易购用户的搜索关键字,在搜索栏输入自清洁空调,海尔自清洁空调排名第一。

而海尔智能自清洁空调新品在苏宁首发上市,将进一步巩固海尔在智能空调领域的领军地位。数据显示,2016年,海尔互联空调(包括智能空调)全球销量第一,在中国,海尔已连续38个月智能空调销量第一。